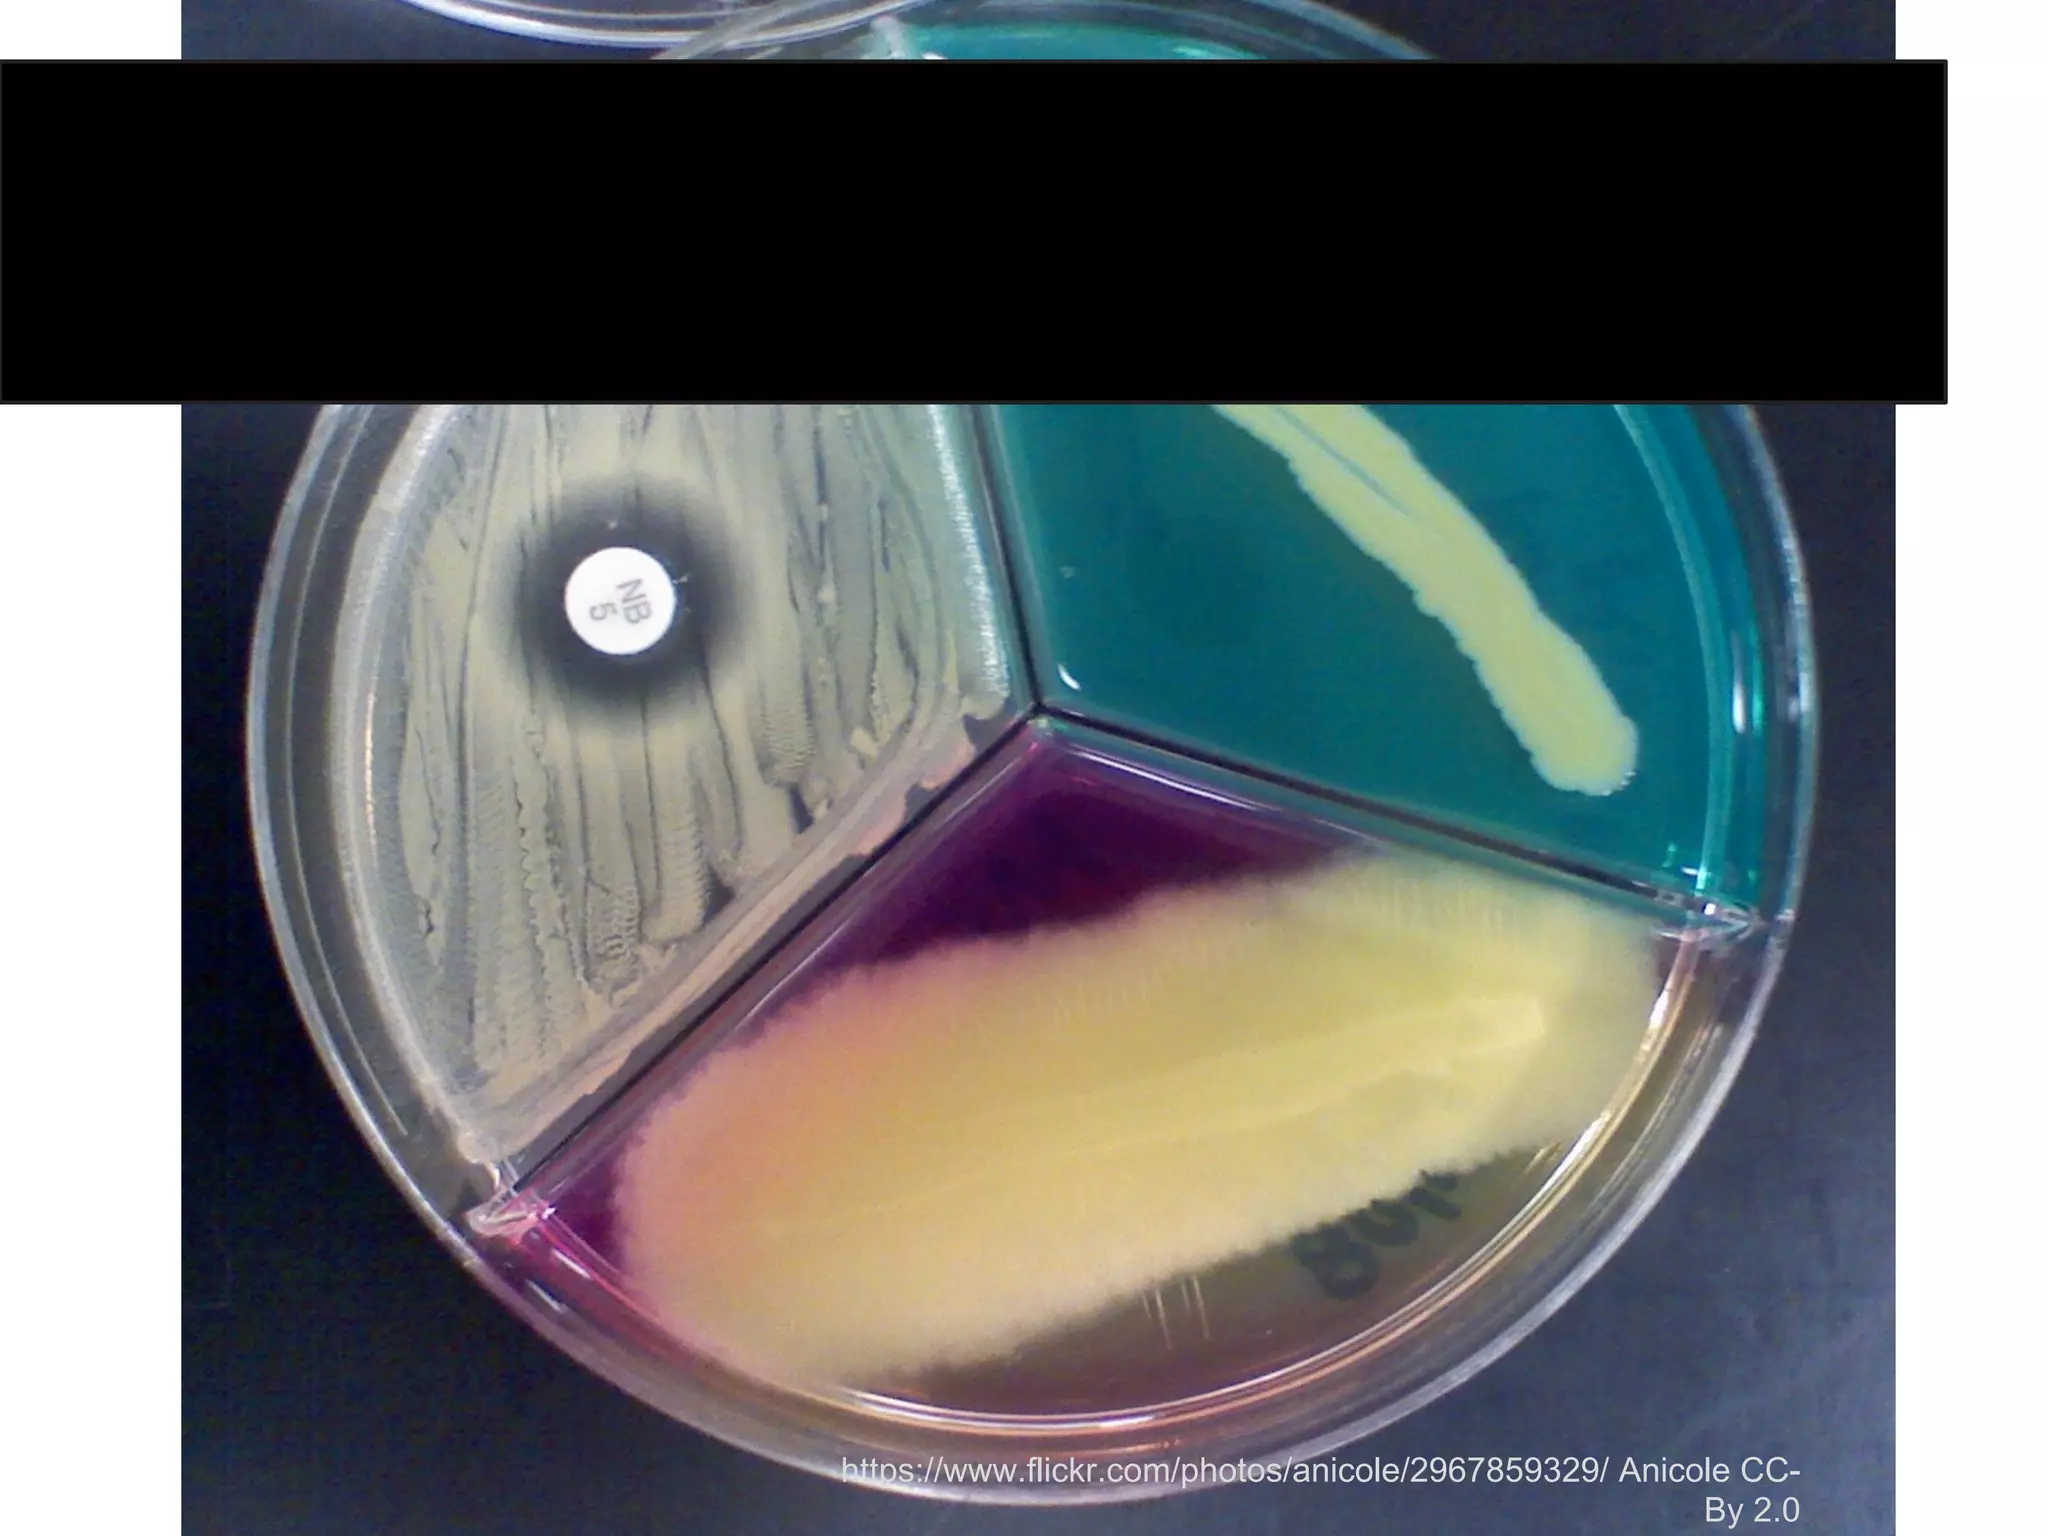
Communities of PracticeChallenges

The document discusses the collaborative efforts of an interdisciplinary group of librarians and researchers in enhancing research data services at various universities. Key activities include assisting with data management plans, providing consultations, and fostering relationships and communities of practice in data management. The future initiatives planned involve workshops, data curation pilots, and efforts to improve information-sharing practices within research environments.














![[ https://twitter.com/notsosternlib/status/580841674366148609 ]](https://image.slidesharecdn.com/marshallrdapfinal-150422145929-conversion-gate02/75/RDAP-15-You-re-in-good-company-Unifying-campus-research-data-services-15-2048.jpg)
















![[ https://rprg.discovery.wisc.edu/Resources/RDS ]](https://image.slidesharecdn.com/marshallrdapfinal-150422145929-conversion-gate02/75/RDAP-15-You-re-in-good-company-Unifying-campus-research-data-services-32-2048.jpg)